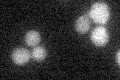
YPL033C
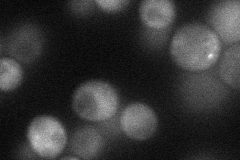
YPL033C
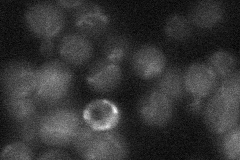
YPL033C

View description
Protein of unknown function; involved in regulation of dNTP production; null mutant suppresses the lethality of lcd1 and rad53 mutations; expression is induced by Kar4p
Localization:
Intensity:
Fold change:
Significance:
-
C’ GFP library in SD
below threshold16.35 -
N' NOP1pr-GFP in SD
cytosol33.3582 -
N' TEF2pr-mCherry in SD

cytosol103.755 -
N' NATIVEpr-GFP in SD
ambiguous12.218 -
N' TEF2pr-VC and Cyto-VN in SD

below threshold23.1623 -
C’ GFP library in SD+DTT

cytosol16.871.03No -
C’ GFP library in SD+H2O2

cytosol16.921.03No -
C’ GFP library in Starvation Media

cytosol18.721.14No -
C’ GFP library on the background of Pup2-DaMP

below threshold -
C’ GFP library on the background of CCT mutant

below threshold17.12431.04663No
